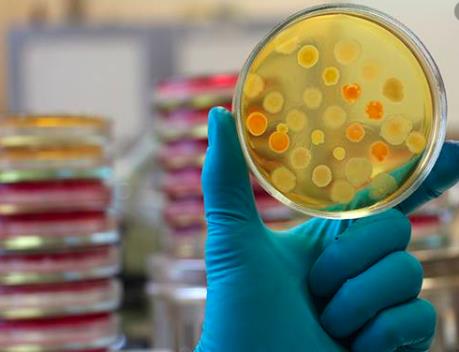
Dịch bệnh viêm phổi do virus Corona: Novacyt giới thiệu phương pháp xét nghiệm mới

Nga đăng ký bộ xét nghiệm phát hiện biến thể mới của virus SARS-CoV-2
Theo thông báo mới đây được đăng tải trên trang mạng của Viện Nghiên cứu dịch tễ trung ương của Rospotrebnadzor (Nga), các nhà khoa học nước này đã đăng ký bộ xét nghiệm đầu tiên trên thế giới phát hiện được biến thể mới của virus SARS-CoV-2 gây bệnh viêm đường hô hấp cấp COVID-19, vốn được phát hiện tại Anh.
Thông báo nêu rõ Viện Nghiên cứu dịch tễ trung ương của Rospotrebnadzor đã phát triển và đăng ký một bộ xét nghiệm phát hiện biến thể mới của virus SARS-CoV-2 phát hiện tại Anh.
Bộ thuốc thử này có tên gọi AmpliSense® SARS-CoV-2-UK-IT. Thông báo cũng lưu ý rằng bộ xét nghiệm mới này phát hiện được đúng biến thể mới và nhấn mạnh đây là bộ xét nghiệm đầu tiên như vậy trên thế giới.
Theo Rospotrebnadzor, kết quả xét nghiệm trên các mẫu lâm sàng nhiễm biến thể mới đã chứng minh bộ thuốc thử có độ chính xác cao. Thông báo khẳng định công nghệ mới có thể được sử dụng để phát triển thuốc thử với khả năng phát hiện bất kỳ biến thể nào khác của virus SARS-CoV-2, cũng như các mầm bệnh truyền nhiễm khác cần xét nghiệm nhanh hàng loạt.
Trong khi đó, theo phóng viên TTXVN tại Sydney, Bộ trưởng Y tế Australia Greg Hunt ngày 15/2 xác nhận lô vaccine đầu tiên do hãng Pfizer sản xuất đã đến Australia và nước này sẽ bắt đầu triển khai tiêm phòng COVID-19 từ đầu tuần tới.Bộ trưởng Hunt nêu rõ 142.000 liều vaccine của Pfizer đã được chuyển từ Bỉ tới Australia một cách an toàn và bảo đảm chất lượng. Trong số 80.000 liều vaccine sẽ được tiêm từ ngày 22/2 tới, 55.000 liều sẽ được phân bổ cho các bang trong cả nước để tiêm chủng cho các nhân viên làm nhiệm vụ cách ly và các nhân viên tuyến đầu khác phải tiếp xúc với người nhập cảnh từ nước ngoài.
Chính phủ liên bang sẽ trực tiếp phân phối 30.000 liều vaccine cho các nhân viên làm việc tại cơ sở chăm sóc người cao tuổi trên khắp Australia. Ông Hunt khẳng định Australia đang trên đà thực hiện mục tiêu tiêm chủng cho 4 triệu người trong tổng số hơn 25 triệu dân vào đầu tháng 4 tới.
Theo kế hoạch, cơ quan Quản lý Sản phẩm Điều trị Australia (TGA) sẽ tiến hành công tác thử nghiệm cuối cùng để bảo đảm vaccine có đủ chất lượng, trước khi được phân phối tới các bệnh viện đầu mối và các trung tâm chăm sóc người cao tuổi trên toàn quốc.
Các lô vaccine khác của Pfizer sẽ tiếp tục được chuyển tới Australia với số lượng khoảng 80.000 liều/tuần, bắt đầu từ đầu tháng 3, trong tổng số 20 triệu liều vaccine được ký kết giữa công ty Pfizer và Chính phủ Australia.
Trong khi đó, cũng vào đầu tháng 3, hơn 3 triệu liều vaccine của AstraZeneca sẽ bắt đầu được vận chuyển tới Australia từ châu Âu. Ngoài ra, còn 47 triệu liều vaccine của AstraZeneca đang được sản xuất tại thành phố Melbourne./.
Tin liên quan
-
![Hòa Bình đưa hệ thống máy xét nghiệm virus SARS-CoV-2 vào sử dụng]() Kinh tế xã hội
Kinh tế xã hội
Hòa Bình đưa hệ thống máy xét nghiệm virus SARS-CoV-2 vào sử dụng
21:15' - 02/04/2020
Trung tâm Kiểm soát Bệnh tật tỉnh Hòa Bình vừa tiếp nhận và chính thức vận hành hệ thống thiết bị hiện đại, đồng bộ chuyên sàng lọc, xét nghiệm mẫu nghi nhiễm virus SARS-CoV-2.
-
![Dịch bệnh viêm phổi do virus Corona: Novacyt giới thiệu phương pháp xét nghiệm mới]() Kinh tế Thế giới
Kinh tế Thế giới
Dịch bệnh viêm phổi do virus Corona: Novacyt giới thiệu phương pháp xét nghiệm mới
18:50' - 31/01/2020
Công ty Novacyt có trụ sở tại Pháp đã giới thiệu phương pháp xét nghiệm mới đối với virus Corona, vốn gây ra dịch viêm phổi nguy hiểm đang lây lan tại nhiều quốc gia trên thế giới.
Tin cùng chuyên mục
-
![Vụ nổ mỏ than Trung Quốc: Khẩn trương tìm kiếm 2 người còn mất tích]() Kinh tế Thế giới
Kinh tế Thế giới
Vụ nổ mỏ than Trung Quốc: Khẩn trương tìm kiếm 2 người còn mất tích
12:44'
Đến thời điểm này, thống kê của cơ quan chức năng xác nhận 82 người thiệt mạng và 2 người mất tích trong vụ nổ mỏ than Trung Quốc.
-
![Sự kiện kinh tế thế giới nổi bật tuần qua]() Kinh tế Thế giới
Kinh tế Thế giới
Sự kiện kinh tế thế giới nổi bật tuần qua
08:34'
Dưới đây mà một số sự kiện kinh tế thế giới nổi bật tuần qua.
-
![Mỹ và Iran sắp đạt thỏa thuận gia hạn ngừng bắn thêm 60 ngày]() Kinh tế Thế giới
Kinh tế Thế giới
Mỹ và Iran sắp đạt thỏa thuận gia hạn ngừng bắn thêm 60 ngày
07:58'
Financial Times cho biết thỏa thuận tiềm năng có thể bao gồm việc từng bước mở lại hoạt động hàng hải qua Eo biển Hormuz, tuyến vận tải năng lượng chiến lược của thế giới.
-
![IMF: EU cần cải cách sâu rộng để kiểm soát nợ công]() Kinh tế Thế giới
Kinh tế Thế giới
IMF: EU cần cải cách sâu rộng để kiểm soát nợ công
06:30'
IMF cũng khuyến nghị EU cần tăng cường liên kết thị trường năng lượng giữa các nước thành viên, tạo điều kiện để dòng tiền tiết kiệm của người dân lưu chuyển dễ dàng hơn.
-
![Kinh tế Pháp phát tín hiệu đáng lo ngại]() Kinh tế Thế giới
Kinh tế Thế giới
Kinh tế Pháp phát tín hiệu đáng lo ngại
14:37' - 23/05/2026
Nhiều tổ chức quốc tế đã đồng loạt hạ dự báo tăng trưởng của Pháp trong năm 2026, làm dấy lên lo ngại về nguy cơ suy thoái kỹ thuật trong những tháng tới.
-
![Nhiều quốc gia nỗ lực tiếp cận nguồn vốn khẩn cấp từ WB]() Kinh tế Thế giới
Kinh tế Thế giới
Nhiều quốc gia nỗ lực tiếp cận nguồn vốn khẩn cấp từ WB
14:36' - 23/05/2026
Nhiều quốc gia đã bắt đầu triển khai các công cụ ứng phó khủng hoảng nhằm nhanh chóng tiếp cận nguồn vốn từ những chương trình hiện có của Ngân hàng Thế giới (WB).
-
![2 công ty thép của Canada phải trả hàng triệu USD vì cáo buộc trốn thuế Mỹ]() Kinh tế Thế giới
Kinh tế Thế giới
2 công ty thép của Canada phải trả hàng triệu USD vì cáo buộc trốn thuế Mỹ
13:36' - 23/05/2026
Hai công ty thép Canada đã đồng ý trả 19 triệu USD để giải quyết các cáo buộc rằng họ cố tình không đóng thuế đúng quy định đối với thép cán phẳng được sản xuất tại châu Âu và châu Á.
-
![World Cup 2026: “Giấc mơ vàng” của Mỹ trước nguy cơ hụt hơi]() Kinh tế Thế giới
Kinh tế Thế giới
World Cup 2026: “Giấc mơ vàng” của Mỹ trước nguy cơ hụt hơi
12:34' - 23/05/2026
World Cup 2026 từng được kỳ vọng sẽ tạo nên một “cơn địa chấn” du lịch tại Mỹ, kéo theo làn sóng người hâm mộ khổng lồ và nguồn thu hàng chục tỷ USD cho nền kinh tế.
-
![Cục Dự trữ Liên bang Mỹ chính thức có Chủ tịch mới]() Kinh tế Thế giới
Kinh tế Thế giới
Cục Dự trữ Liên bang Mỹ chính thức có Chủ tịch mới
08:11' - 23/05/2026
Tân Chủ tịch Cục Dự trữ Liên bang Mỹ (Fed) Kevin Warsh ngày 22/5 (giờ địa phương) đã tuyên thệ nhậm chức tại Nhà Trắng.

 Nga đã đăng ký bộ xét nghiệm đầu tiên trên thế giới phát hiện được biến thể mới của virus SARS-CoV-2. Ảnh minh họa: Reuters
Nga đã đăng ký bộ xét nghiệm đầu tiên trên thế giới phát hiện được biến thể mới của virus SARS-CoV-2. Ảnh minh họa: Reuters